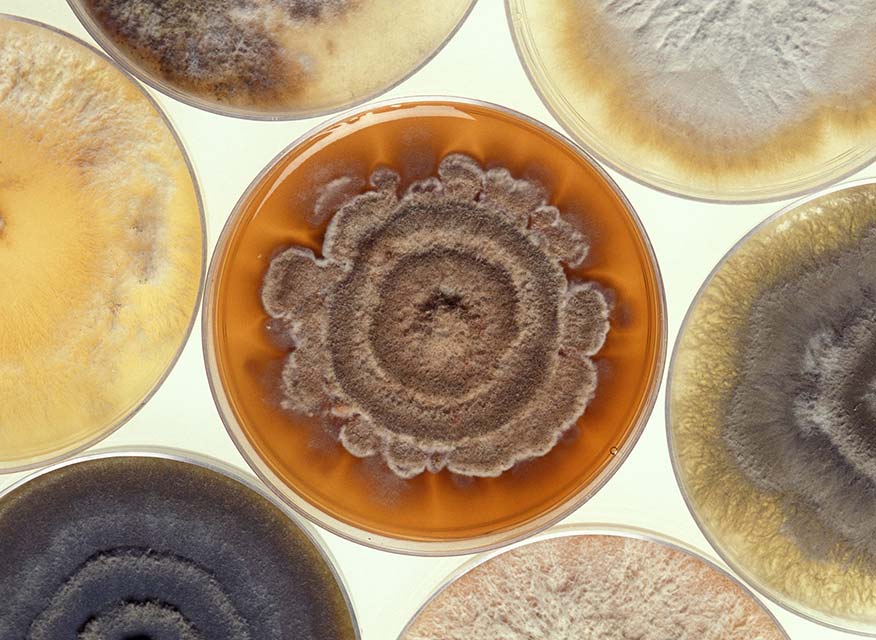

Produtos
A Fungiperfect desenvolve produtos para produção de cogumelos desde 2005. Durante estes anos criámos, representámos e desenvolvemos vários produtos e equipamentos que necessita para produzir cogumelos e para colher cogumelos selvagens.
Kits de produção de cogumelos
Fáceis e práticos (produção 100% garantida)
Os nossos kits produção de cogumelos são a forma ideal de iniciar a sua produção. Garantimos 100 % de eficácia – siga as regras que acompanham o kit. Caso ocorra algum problema com kit durante o transporte nós enviaremos um novo e prontinho a produzir. Consulte a nossa loja online.

Micélio e Culturas
As nossas culturas são provenientes de espécimes com elevado vigor e excelente aspeto. Todas as culturas foram submetidas a rigorosos testes de produção e provaram ter elevado potencial de produtividade.
O micélio da Fungiperfect é comercializado na 3.ª geração após a cultura mãe e tem por base 3 materiais fundamentais: serrim de madeira, grão de cereais e cavilhas de madeira. Antes do envio ao cliente, é feita uma verificação rigorosa da vitalidade do micélio. Veja a nossa lista de micélios.

Materiais de laboratório e produção
Se pretende iniciar um pequeno laboratório ou uma pequena produção em sua casa, a Fungiperfect fornece todos os materiais de base (que testámos intensivamente e que utilizamos atualmente).
Não comercializamos materiais correntes (como palha de cereais, água destilada, etc.), mas damos sugestões sobre onde adquirir.
Veja a nossa lista de materiais de laboratório e produção.
Equipamento de laboratório e de produção
Dominar técnicas simples de produção de micélio é fundamental para viabilizar a sua produção de cogumelos.
Ao longo do tempo fomos trabalhando com produtores e desenvolvendo soluções simples de baixo custo que podem ajudar na sua produção de cogumelos.
Por isso a Fungiperfect disponibiliza equipamentos funcionais e de baixo custo, que permitem montar um pequeno laboratório em espaços pequenos da sua casa (um armário, por exemplo).
Veja a nossa lista de equipamentos.

Colheita de cogumelos selvagens
A identificação de cogumelos silvestres pode ser feita apenas com observação visual.
Estamos a desenvolver um pequeno guia visual dos cogumelos mais importantes de Portugal e pode prestar o seu contributo (com informação, fotos e outros). Consulte.
Antes de sair para o campo, garanta que leva a navalha ideal, uma roupa confortável, um guia de identificação de cogumelos, com boas fotografias e de fácil interpretação, um cesto de vime bastante largo e raso e um localizador GPS ou telemóvel.
Siga as nossas regras de boas práticas, para colher cogumelos de forma responsável.

